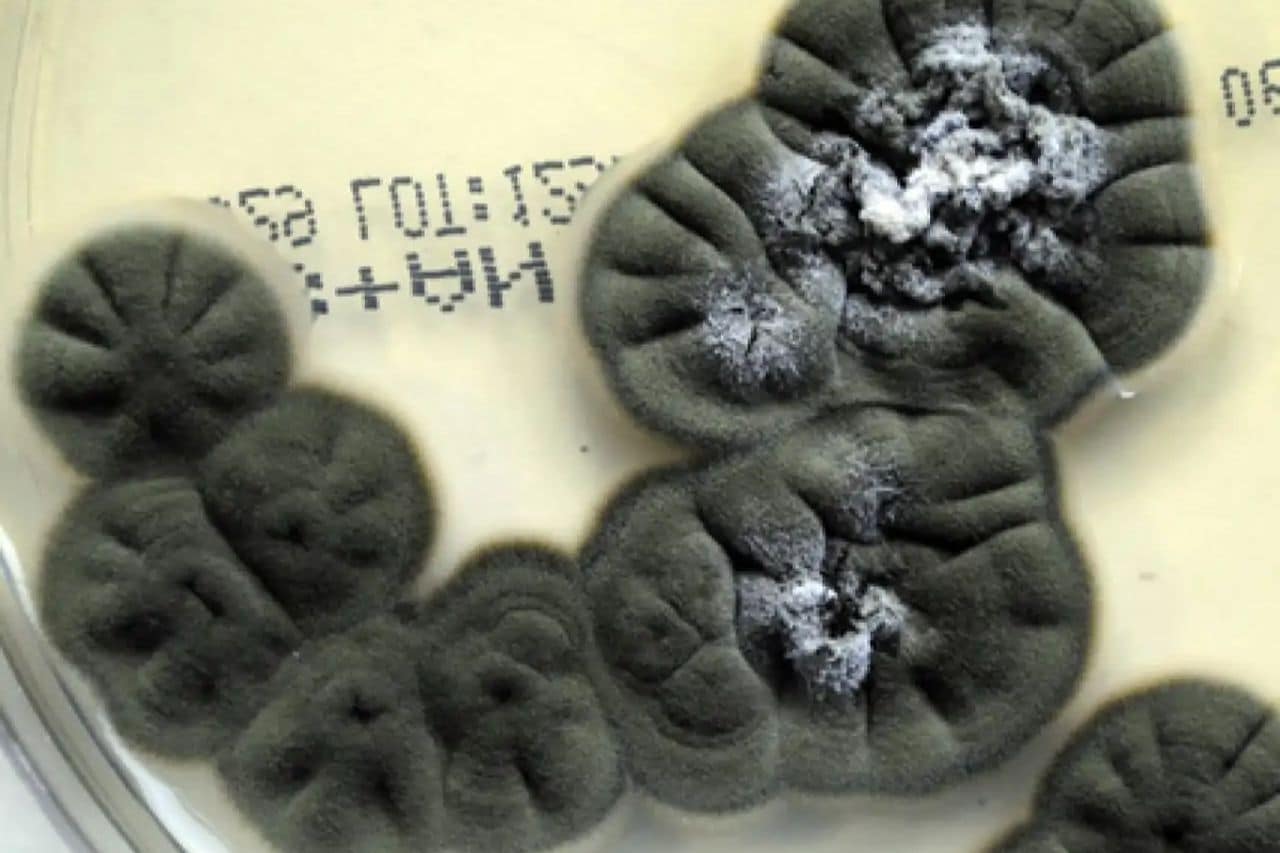

Cuando en grupo de científicos volvieron a internarse en las ruinas del reactor 4 de Chernóbil descubrieron algo que parecía desafiar toda lógica biológica, colonias de hongos negros creciendo sobre las paredes fuertemente irradiadas.
En uno de los lugares más hostiles del planeta, donde casi nada debería sobrevivir, estos hongos no solo persistían. Algunos parecían orientarse hacia la radiación, como si estuvieran utilizándola.
Este fenómeno abrió una nueva pregunta científica: ¿es posible que exista vida capaz de aprovechar la radiación ionizante como fuente de energía?
Los hongos radiotróficos y la melanina activa
Los hongos encontrados en Chernóbil pertenecen a especies melanizadas, con paredes celulares cargadas de melanina, el mismo pigmento que protege la piel humana frente a los rayos UV.
Entre las especies identificadas destacan Cladosporium sphaerospermum, Cryptococcus neoformans y Wangiella dermatitidis. Los científicos los califican como hongos radiotróficos, organismos capaces de crecer mejor cuando están expuestos a radiación gamma.
Es un fenómeno bautizado como radiosíntesis, un análogo extremo de la fotosíntesis, pero alimentado por radiación ionizante. La microbióloga Ekaterina Dadachova, una de las investigadoras pioneras en este campo, afirma:
“La melanina cambia sus propiedades electrónicas cuando se expone a la radiación, y esto permite que los hongos generen más energía para crecer.”
En un estudio de 2007, su equipo demostró que estos hongos incrementaban su biomasa en presencia de radiación, mientras que sus versiones mutantes sin melanina no mostraban ninguna ventaja.

Los experimentos que cambiaron la narrativa científica
En laboratorio, los hongos melanizados fueron expuestos a niveles de radiación 500 veces superiores al fondo natural, mostrando resultados contundentes como los siguientes:
- Crecieron más rápido bajo radiación que en condiciones normales.
- Mostraron mayor actividad metabólica.
- Aumentaron la incorporación de nutrientes clave.
- Exhibieron radiotropismo positivo: tendencia a moverse hacia la fuente radiactiva.
¿La explicación científica? Según el equipo de Dadachova “La radiación ionizante reorganiza la melanina, permitiendo que transfiera electrones de manera más eficiente. Esto aumenta el potencial energético del hongo.”
Este hallazgo abrió una discusión global sobre si la vida, en condiciones extremas, puede desarrollar mecanismos para aprovechar energías que consideramos letales.
Chernóbil como laboratorio evolutivo
Los investigadores que han muestreado los suelos, hormigón y metal de la zona de exclusión han identificado cientos de especies de hongos, pero los melanizados dominan en las áreas de mayor radiación.
Algunas colonias encontradas en el interior del reactor parecían orientarse hacia puntos calientes de radiación, un comportamiento que los investigadores interpretan como una señal de adaptación energética.
El ecólogo microbiano Kasthuri Venkateswaran, investigador de la NASA, lo resume así: “La vida siempre encuentra una forma de adaptarse. Los hongos de Chernóbil no solo sobreviven, parecen haber convertido la radiación en una ventaja competitiva.”
¿De verdad ‘comen’ radiación?
El término “hongos que comen radiación” se popularizó rápidamente, pero la comunidad científica prefiere matizar:
- No se ha demostrado que la radiación sea su única fuente de energía.
- Sí hay evidencia de que pueden convertir parte de esa energía en procesos metabólicos.
- La melanina actúa como una superficie captadora que canaliza electrones de forma más eficiente.
Algunos expertos sostienen que aún es pronto para afirmar que realizan radiosíntesis completa: “No sabemos si es un mecanismo primario de energía o una respuesta adaptativa al estrés ambiental.”
Pero el consenso es claro. La radiación no los daña como a la mayoría de la vida, sino que los fortalece.
¿De Chernóbil a Marte? la NASA pone la mirada en los hongos negros
La fascinación por estos organismos llegó hasta las agencias espaciales. La NASA ha estudiado hongos de Chernóbil como posibles escudos biológicos autorreparables contra la radiación espacial.
En experimentos realizados en la Estación Espacial Internacional (ISS), una fina capa del hongo Cladosporium sphaerospermum logró:
- Reducir la radiación que atravesaba la muestra.
- Mantener actividad metabólica en condiciones extremas.
- Crecer más rápido cerca de fuentes radiactivas.
- Declaración de un investigador de la NASA.
Venkateswaran añade: “Imagina materiales vivos capaces de proteger a los astronautas. Esto podría cambiar la forma en que concebimos las misiones espaciales de largo alcance.”
La idea de un escudo vivo para viajes a Marte ya no parece ciencia ficción.
Bioremediación ¿aliados en desastres nucleares?
Los hongos radiotróficos podrían tener aplicaciones terrestres cruciales:
- Atenuación de radiación en estructuras nucleares dañadas.
- Descontaminación biológica en zonas radiactivas.
- Tratamiento de residuos y superficies irradiadas.
- Protección de infraestructuras civiles sensibles.
No obstante, expertos en biotecnología señalan que falta comprender:
- Los límites ecológicos de estos hongos.
- Su comportamiento a gran escala.
- Los riesgos de introducirlos en ecosistemas no irradiados.
- El potencial es enorme, pero aún requiere cautela científica.
Nueva definición de “vida”
Los hongos negros de Chernóbil son un recordatorio de que la vida siempre encuentra formas inesperadas de persistir. Donde la radiación debería borrar toda posibilidad de crecimiento, estos organismos han desarrollado una biología que desafía los límites conocidos.
Son testigos silenciosos, pero también portadores de posibilidades para el futuro: desde tecnologías espaciales hasta nuevas estrategias de bioremediación. En un mundo que enfrenta riesgos nucleares y sueña con explorar otros planetas, comprender cómo prosperan estos hongos no es solo curiosidad científica.
Es una ventana a un futuro donde la vida, incluso la más humilde, podría ayudarnos a sobrevivir en los lugares más hostiles del universo.

